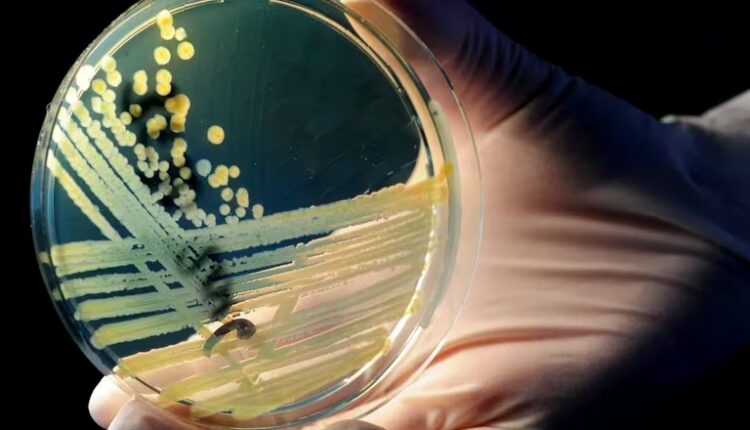

El aumento de la resistencia a los antibióticos podría causar 39 millones de muertes para 2050
Un estudio global publicado en la revista The Lancet alertó por la suba de infecciones que los medicamentos ya no pueden tratar de manera efectiva debido a la resistencia antimicrobiana. Los mayores de 70 años son el grupo más vulnerable
:quality(85)/cloudfront-us-east-1.images.arcpublishing.com/infobae/7XUHRMMK3VASLNLLDSGMO522OI.jpg%20420w) El análisis global en 204 países destacó el incremento alarmante de la resistencia a los antibióticos entre las personas mayores de 70 años (EPA/Julian Stratenschulte/Archivo)
El análisis global en 204 países destacó el incremento alarmante de la resistencia a los antibióticos entre las personas mayores de 70 años (EPA/Julian Stratenschulte/Archivo)El mundo se enfrenta a una crisis de salud pública que avanza silenciosamente y amenaza con revertir décadas de progreso médico: la resistencia antimicrobiana (RAM). Un estudio publicado ayer en la prestigiosa revista científica The Lancet estimó que más de 39 millones de personas podrían morir en las próximas décadas debido a infecciones que los antibióticos ya no pueden tratar de manera efectiva.
El análisis, que abarca 204 países y territorios, proyecta un aumento alarmante de muertes directamente relacionadas con la RAM para el año 2050, especialmente entre las personas mayores de 70 años.
El problema de la resistencia a los antimicrobianos no es nuevo para los investigadores, desde la década de 1990, los antibióticos que alguna vez revolucionaron la medicina moderna, al salvar millones de vidas, han perdido su eficacia debido a múltiples causas, entre ellas, a la capacidad de adaptación de las bacterias y al uso excesivo sin seguir las indicaciones médicas.
La RAM ocurre cuando los patógenos evolucionan y se vuelven inmunes a los tratamientos actuales, lo que provoca que infecciones comunes, como la neumonía o las infecciones postoperatorias, sean nuevamente mortales.
El nuevo estudio del Proyecto de Investigación Global sobre Resistencia a los Antimicrobianos (GRAM) es el primer análisis mundial de las tendencias de la resistencia a los antimicrobianos (RAM) a lo largo del tiempo. El análisis advirtió que más de un millón de personas murieron cada año como resultado de la RAM entre 1990 y 2021.
:quality(85)/cloudfront-us-east-1.images.arcpublishing.com/infobae/ROUK6MPVGRFHZLRNH7KD5YOO5E.jpg%20992w) La bacteria Salmonella que se transmite por el consumo de comida contaminada se encuentra en la lista de los 15 patógenos resistentes de la OMS. Está en la categoría de Alta prioridad (NIAID)
La bacteria Salmonella que se transmite por el consumo de comida contaminada se encuentra en la lista de los 15 patógenos resistentes de la OMS. Está en la categoría de Alta prioridad (NIAID)El proyecto, liderado por el doctor Mohsen Naghavi, investigador del Instituto de Métricas de Salud (IHME) de la Universidad de Washington de los Estados Unidos señaló que solo en 2021, más de un millón de personas murieron en el mundo a causa de infecciones resistentes a los antimicrobianos. Si las tendencias actuales continúan, para 2050, las muertes anuales por RAM crecerán un 70 %, con 1,91 millones de fallecimientos. Además, se prevé que el número de muertes en las que las bacterias resistentes desempeñen un papel indirecto se eleve hasta los 8,22 millones por año.
“Los medicamentos antimicrobianos son una de las piedras angulares de la atención médica moderna, y el aumento de la resistencia a ellos es un motivo importante de preocupación. Estos hallazgos resaltan que la RAM ha sido una amenaza significativa para la salud mundial durante décadas y que esta amenaza está creciendo”, agregó Naghavi.
El nuevo estudio del Proyecto de Investigación Global sobre Resistencia a los Antimicrobianos (GRAM) es el primer análisis mundial de las tendencias de la resistencia a los antimicrobianos (RAM) a lo largo del tiempo.
En palabras de Luis Ostrosky, jefe de enfermedades infecciosas en UTHealth Houston, “la medicina depende del uso de antibióticos para cosas tan rutinarias como cirugías o trasplantes”. Según el experto, el mundo se encuentra “en un tiempo muy peligroso”, ya que el aumento de la RAM significa que infecciones que solían ser tratables ahora escapan al control médico.
“Para evitar que esto se convierta en una realidad mortal, necesitamos urgentemente nuevas estrategias para reducir el riesgo de infecciones graves mediante vacunas, nuevos medicamentos, una mejor atención sanitaria, un mejor acceso a los antibióticos existentes y orientación sobre cómo utilizarlos de forma más eficaz”, dijo el autor del estudio, el Dr. Stein Emil Vollset, del Instituto Noruego de Salud Pública y profesor afiliado del IHME.
Los adultos mayores y los niños son los grupos más vulnerables
:quality(85)/cloudfront-us-east-1.images.arcpublishing.com/infobae/WHEKO7JRRFFCHOARUFIQFSS4M4.jpg%20420w) Sólo en 2021, más de un millón de personas murieron debido a infecciones resistentes a los antimicrobianos (Imagen Ilustrativa Infobae)
Sólo en 2021, más de un millón de personas murieron debido a infecciones resistentes a los antimicrobianos (Imagen Ilustrativa Infobae)El estudio de The Lancet también muestra una tendencia dispar entre grupos etarios. Mientras que las muertes por resistencia antimicrobiana entre los niños menores de cinco años se redujeron en más del 50 % entre 1990 y 2021, los mayores de 70 años se enfrentan a un panorama preocupante. En este grupo, las muertes por infecciones resistentes aumentaron en un 80 % y se espera que esta cifra se duplique en las próximas décadas.
Los países de altos ingresos, como Estados Unidos y varios países europeos, verán un incremento del 72 % en las muertes relacionadas con RAM para 2050. Sin embargo, las regiones más afectadas serán las del norte de África y el Oriente Próximo, donde se proyecta un aumento del 234 % en las muertes en personas mayores.
A pesar de la disminución en los fallecimientos entre los niños pequeños, los expertos advierten que las infecciones resistentes son cada vez más difíciles de tratar cuando ocurren, lo que pone de manifiesto la necesidad urgente de intervenciones preventivas. Kevin Ikuta, investigador de la Universidad de California en Los Ángeles (UCLA) y coautor del estudio, lo resume así: “La amenaza de la resistencia a los antimicrobianos para las personas mayores solo aumentará a medida que la población envejezca”.
El informe de The Lancet subraya que, de no tomar medidas urgentes, esta crisis sanitaria global podría desencadenar una catástrofe. No obstante, también identifica varias acciones que podrían salvar 92 millones de vidas entre 2025 y 2050. Entre ellas, la mejora del acceso a los antibióticos, el fortalecimiento de los sistemas de salud y la investigación de nuevos medicamentos juegan un papel crucial.
:quality(85)/cloudfront-us-east-1.images.arcpublishing.com/infobae/JC66KVIM6FAFPOCLSLHMT6JJEA.jpg%20420w) Para disminuir la resistencia, recomiendan evitar el mal uso de antibióticos y promover su empleo responsable (Getty)
Para disminuir la resistencia, recomiendan evitar el mal uso de antibióticos y promover su empleo responsable (Getty)Uno de los hallazgos más preocupantes del estudio es la proyección de que estamos entrando en lo que los expertos denominan la era posantibiótica, un momento en el que las infecciones bacterianas ya no responderán a los medicamentos conocidos. “Estamos llegando a una era en la que ya no tendremos recursos que funcionen”, alerta Ostrosky.
La Organización Mundial de la Salud (OMS) calificó a la resistencia antimicrobiana como una de las 10 principales amenazas para la salud de la humanidad. La institución ha advertido que infecciones como la neumonía, la tuberculosis y la gonorrea, que se controlaban con antibióticos, podrían volver a convertirse en causas comunes de muerte si no se desarrollan nuevos tratamientos.
Paradójicamente, la pandemia de COVID-19 ofreció un breve respiro en la tendencia al alza de muertes por RAM. El distanciamiento social y las medidas de control de enfermedades implementadas para contener el virus redujeron la carga de infecciones respiratorias no relacionadas con el COVID, lo que llevó a una disminución temporal de las muertes por RAM en 2021. Sin embargo, los expertos advierten que esta caída es temporal y no representa una solución a largo plazo

Los comentarios están cerrados.